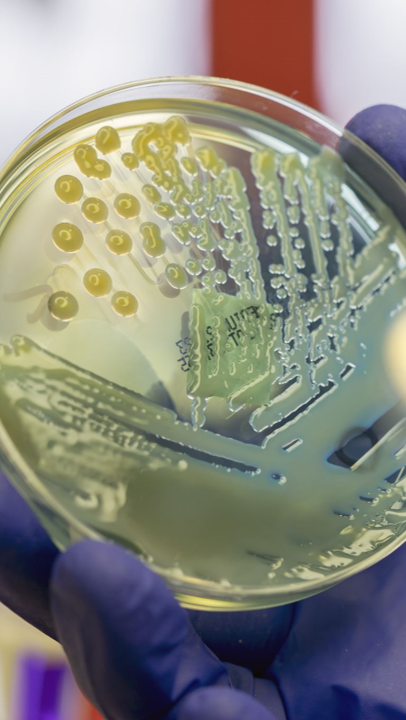

Pathogens
| Neonates | Staph Aureus, Enterobacter, Group A and B Streptococcus |
| Infants | Staph Aureus, Group A Strep, Haemophilus Influenzae, Enterobacter |
| Children + Adolescents | Staph Aureus, Group A Strep, H’flu, Enterobacter |
| Adults | Staph Aureus |
| Sickle Cell Patients | Salmonella |
We have covered how Osteomyelitis is a disease process of infection, now let’s talk about what pathogens might be responsible.
The pathogens that should be 'on your radar' are shown in the table. Notice they change somewhat, however the highlighted pathogen gives it away in each category.
While it is likely that Staph Aureus is going to be the main culprit for Osteomyelitis, in untypical patients, especially children and neonates, it is important to include cover for the slightly more unusual organisms that may be present in active Osteomyelitis.
Remember to refer to the local formulary and local health alerts as each board will be slightly different.